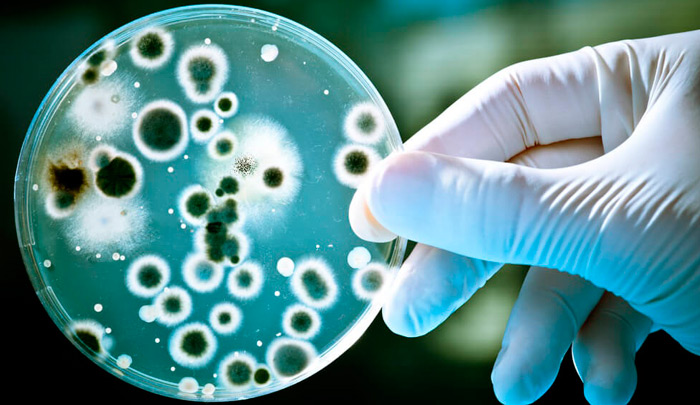
патогенные микроорганизмы — возбудители

Инфекционно-токсический шок (ИТШ) развивается на фоне различных болезней как тяжёлое осложнение воспалительного процесса и представляет прямую угрозу жизни человека. Тревожный сигнал — резкое ухудшение состояния пациента.
Для того чтобы быстро принять решение, необходимо владеть информацией и иметь ответы на вопросы заранее, до возникновения критического состояния. Поэтому давайте узнаем, что такое инфекционно-токсический шок, в чём причины его появления, каковы симптомы, а также о мерах первой помощи, принципах лечения и возможных последствиях.
Что такое инфекционно-токсический шок
Это экстренное состояние, вызванное воздействием на организм человека болезнетворных микроорганизмов и продуктов их жизнедеятельности.
Слово шок переводится с французского и английского языка одинаково — потрясение, удар. Историки медицины считают, что термин появился при переводе с французского на английский книги хирурга Анри Франсуа Ледрана, состоящего консультантом при армии Людовика XV. Безвестный переводчик применил такой термин для описания состояния пациентов после огнестрельной травмы.
Сегодня слово «шок» используют в повседневной речи, чтобы описать сильные чувства. В медицине же он рассматривается как состояние декомпенсации (срыва) защитных механизмов в ответ на действие повреждающих факторов.
В рассуждениях о патогенезе шока всегда упоминаются пусковые механизмы. При геморрагическом шоке — это острая кровопотеря, при кардиогенном — снижение сократительной функции миокарда.
Патогенез
Инфекционно-токсического шок любой этиологии запускает генерализованную реакцию организма. В ответ на выделение токсинов бактериями иммунная система включает защитные механизмы.
Учёные называют этот процесс — медиаторная буря. В кровоток выбрасываются в больших количествах гормоны и биологически активные вещества. Они влияют на кровеносные сосуды, проницаемость их стенки. Но реакция выходит за пределы одного органа или системы. В этом главная опасность инфекционно-токсического шока.
Ухудшается кровоснабжение головного мозга, сердца, лёгких, печени, почек, желудочно-кишечного тракта. Процесс называется гипоперфузией и является ведущим симптом инфекционно-токсического шока. В результате попытки организма защитить себя, приводят к развитию порочного круга.
Причины
Инфекционные заболевания вызывают патогенные микроорганизмы — возбудители. Чаще всего инфекционно-токсический шок развивается под воздействием бактерий. В 2/3 случаев это грамотрицательные микробы. Оставшаяся треть заболеваний приходится на влияние грамположительной флоры.
Инфекционно-токсический шок бактериального происхождения развивается как осложнение следующих заболеваний:
- кишечных инфекций (сальмонеллёза);
- перитонита;
- брюшного тифа;
- менингококцемии — генерализованной формы менингококковой инфекции;
- лептоспироза;
- дифтерии;
- туберкулёза.
Инфекционно-токсический шок вирусного происхождение развивается при гриппе. А вот при сепсисе или пневмонии возбудитель может относиться к одной из трёх категорий — бактериям, вирусам, грибам.
Стадии
Существует несколько подходов классификации инфекционно-токсического шока. Вне зависимости от этиологического фактора (причин) в его течении возможны следующие стадии развития.
Классификация инфекционно-токсического шока по стадиям R. M. Hardaway (1963)
| Стадия обратимого шока | Стадия необратимого шока | ||
| Фазы обратимого шока | Сознание отсутствует. Дыхание грубо нарушено. Пульс на периферической артерии не определяется. Симптомы ДВС-синдрома. | ||
| Раннего | Позднего | Устойчивого | |
| Не всегда диагностируется.
Пациент жалуется на озноб, боли в мышцах, жажду. Наблюдается беспокойство, двигательное возбуждение, неадекватная оценка тяжести собственного состояния. При осмотре кожа бледная, реже розовая, тёплая на ощупь, может быть слегка влажная. Артериальное давление (АД) не снижается или даже незначительно повышается. Пульс частый. Дыхание учащено. Диурез (выделение мочи) снижен. |
Человек становится вялым, безразличным, лежит с закрытыми глазами, не хочет вступать в контакт.
Усиливается бледность кожи, появляется «мраморный» рисунок, синюшность кончика носа, губ, ушей, концевых фаланг пальцев. На ощупь кожа становится холодная и влажная. Наблюдается постепенное снижение АД и повышение частоты пульса (тахикардия). Нарастает одышка. Температура тела снижается до субфебрильной или нормальной. На коже может появиться сыпь. |
Сознание угнетается вплоть до комы. Кожный покров синюшный. Дыхание поверхностное частотой более 30 вдохов в минуту, неритмичное.
Тахикардия нарастает, АД снижено (могут возникнуть затруднения при его определении). Диурез отсутствует. Температура тела ниже нормальных значений. Признаки ДВС-синдрома (блокада микроциркуляции тканей с последующими нарушениями свёртывания крови). |
|
Читайте также: Синдром дырявого кишечника какие анализы сдавать
Клиническая классификация степеней шока В. И. Покровского с соавторами (1976) и В. Г. Чайцева (1982) характеризует инфекционно-токсический шок при менингококковой инфекции.
Основным критерием тяжести является индекс Альговера. Это соотношение между частотой пульса и систолическим артериальным давлением. Он отражает степень нарушения микроциркуляции в органах, в соответствии с глубиной шока.
Отсюда ещё одно название — шоковый индекс (ШИ). В норме этот показатель составляет около 0,5. При явлениях шока он увеличивается:
- I степень — до 1,0;
- II степень — от 1,0 до 1,5;
- III степень — свыше 1,5.
Шоковый индекс используется в совокупности с клиническими признаками. Не всегда симптомы выражены настолько ярко, чтобы можно было отличить одну фазу от другой. При наблюдении за пациентом важно замечать динамику его состояния.
Понятие сепсиса в последние годы получило новую трактовку. В основе критического состояния лежит синдром системной воспалительной реакции (ССВР) — ответ со стороны организма на действие агрессивных факторов, таких как оперативное вмешательство, травмы, инфекционный процесс. Сепсис — это синдром системной воспалительной реакции на внедрение в организм патогенных микроорганизмов. Поэтому часть авторов проводят аналогию между инфекционно-токсическим и септическим шоком, который получил в МКБ-10 код A 41,9.
Первые признаки
Инфекционно-токсический шок развивается на фоне продолжающейся болезни. Однако, существуют молниеносные формы, при которых симптомы проявляются в короткий срок. Таким примером является менингококковая инфекция, осложнённая шоком. У пациента появляются следующие первые признаки развития инфекционно-токсического шока:
- резкая слабость;
- у детей раннего возраста монотонный крик, выбухание и напряжение большого родничка;
- сильная боль в мышцах, различных отделах живота, головная боль;
- неукротимая рвота, не приносящая облегчения;
- быстрое распространение сыпи на коже лица, слизистых оболочках;
- изменения сознания в зависимости от стадии шока;
- судороги;
- частое поверхностное дыхание;
- артериальная гипотония (снижение АД), тахикардия (ШИ 1,5–2,0);
- повышение температуры тела до 39–41 0С или ниже 36 0С.
Признаки могут проявляться в различной степени. Это зависит от возраста пациента, его исходного состояния, основного заболевания, проводимого лечения. Например, первые признаки шока при лептоспирозе может спровоцировать антибактериальная терапия — бактерицидное действие препаратов вызывает массивное попадание токсинов в кровь.
Симптомы
Особенности течения инфекционно-токсического шока при различных заболеваниях связаны с проявлением ведущих синдромов (комплекса характерных симптомов).
- При менингококковых инфекциях преобладают геморрагический синдром, поражения центральной нервной системы. При гриппе этот синдром тоже присутствует, но его интенсивность выражена меньше.
- При пневмонии ведущие симптомы: острая дыхательная недостаточность — одышка, дыхание с частотой более 30 раз в минуту; признаки интоксикации — гипертермия более 39 0С, тахикардия, изменения сознания.
- При дифтерии зева наблюдаются признаки инфекционно-токсического миокардита, нефроза. При увеличении лимфоузлов появляется отёк шейной клетчатки, распространяющийся вниз до ключиц. Эти симптомы в сочетании с дифтерийной плёнкой вызывает острую дыхательную недостаточность.
- При кишечных инфекциях тяжесть состояния обусловлена действием энтеротоксинов, вызывающих диарею с последующим обезвоживанием.
- У детей симптомы инфекционно-токсического шока могут несколько отличаться. При дифтерии наблюдается поражение миокарда, почек, параличи нёба (поперхивание, гнусавый голос, вытекание жидкой пищи через нос), косоглазие, развитие пневмонии. При лептоспирозе тяжесть состояния обусловлена поражением почек и селезёнки.
Полную картину развития инфекционно-токсического шока может оценить только врач. Поэтому при появлении симптомов, угрожающих жизни больного человека, необходимо немедленно вызывать «скорую помощь».
Первая помощь
Федеральный закон №323-ФЗ, утверждённый в 2011 году и действующий сегодня с поправками, принятыми марте 2019 г., описывает 3 формы оказания медицинской помощи — экстренную, неотложную, плановую. Инфекционно-токсический шок, развивающийся как осложнение тяжёлого заболевания, требует экстренной формы оказания медицинской помощи. Это состояние, которое представляет угрозу жизни человека. Пациентов с такой патологией лечат в отделении реанимации, интенсивной терапии. И если по каким-либо причинам, пострадавший находится вне медицинского учреждения, первое, что необходимо сделать — вызвать «скорую помощь».
Алгоритм первой помощи при инфекционно-токсическом шоке, который развился в молниеносной форме (за несколько часов) включает:
- вызвать «скорую помощь»;
- до приезда медицинских специалистов не оставлять пострадавшего одного, наблюдать за сознанием, дыханием, артериальным давлением, выделением мочи, температурой тела;
- при угнетении сознания, снижении артериального давления — уложить горизонтально, приподняв ноги;
- при отсутствии ясного сознания — не поить, так как возможна аспирация желудочного содержимого (попадание рвотных масс в дыхательные пути);
- при жалобах на сильную жажду смачивать рот салфеткой с водой;
- при терминальных состояниях — проводить сердечно-лёгочную реанимацию.
Читайте также: Синдром пустого турецкого седла лечение народными средствами
Необходимым дополнением к алгоритму первой помощи при инфекционно-токсическом шоке, будет информация о том, что на официальном сайте ГБУ Москвы «Станция скорой и неотложной медицинской помощи им. А.С. Пучкова» имеется телефон врачебно-консультативного пульта службы скорой и неотложной медицинской помощи. Позвонив по номеру 8 (495) 620–42–33, пострадавший или его близкие могут получить предварительную консультацию, в первую очередь по вопросу есть ли угроза для жизни человека, а также рекомендации дальнейших действий.
Диагностика
Своевременно поставить диагноз инфекционно-токсический шок можно на основе данных клинических, лабораторных, аппаратных методов.
Диагностические критерии инфекционно-токсического шока:
- повышение или снижение температуры тела, ознобы;
- нарушения сознания;
- уровень артериального давления и частоты сердечных сокращений в динамике;
- ритмичность и частота дыхательных движений;
- признаки расстройства микроциркуляции крови — цвет, температура кожных покровов;
- диурез;
- наличие дифференциальных признаков — рвота, диарея, сыпь на коже и слизистых, неврологические нарушения, «острый живот».
Дифференциальная диагностика проводится для уточнения диагноза при сходных симптомах и синдромах. В случае инфекционно-токсического шока она заключается в выявлении возбудителя основного заболевания, опираясь на клиническую картину и данные бактериальных посевов мокроты, кала, крови, мазка из зева и носа. Для эффективного лечения определяют чувствительность возбудителя к различным препаратам.
Лабораторная диагностика при инфекционно-токсическом шоке включает:
- общий анализ крови с лейкоцитарной формулой;
- биохимический анализ;
- электролиты крови;
- коагулограмму (характеризует состояние системы свёртывания крови);
- анализ кислотно-основного состояния крови;
- общий анализ мочи.
Данные клинических и лабораторных исследований дополняют ЭКГ, рентгенологические методы, компьютерная томография, УЗИ органов.
Лечение
Интенсивная терапия инфекционно-токсического шока проводится в условиях отделения реанимации. Она включает круглосуточный мониторинг данных о состоянии пациента, коррекцию лечения, на основе лабораторных анализов, аппаратных исследований, уход за кожными покровами, контроль диуреза.
Клинические рекомендации
В основе лечения и реабилитации инфекционно-токсического шока лежат следующие клинические рекомендации.
- Санация очага инфекции. Примером служит оперативное вмешательство при перитоните, когда хирурги удаляют из брюшной полости очаг воспаления, устраняют причину заболевания, например, острый аппендицит или абсцессы.
- Рациональная терапия против возбудителя инфекционного процесса — антибактериальная, противовирусная, антифунгальная (противогрибковая). Препараты назначают на основе бактериальных посевов на чувствительность.
- Лекарственные средства, повышающие устойчивость клеток головного мозга к гипоксии.
- Заместительная терапия функции коры надпочечников — введение кортикостероидов.
- Инфузионная терапия при инфекционно-токсическом шоке предназначена для восполнения жидкости, электролитов, восстановления кислотно-основного состава крови.
- Коррекция иммунного статуса с применением иммуноглобулинов.
- Поддержание кровообращения, стабилизация артериального давления, частоты сердечных сокращений позволяет восстановить микроциркуляцию в тканях и поддержать функции органов.
- В зависимости от показаний проводится респираторная поддержка. Пациента переводят на аппарат искусственной вентиляции лёгких.
- Коррекция патологических симптомов основного заболевания, осложнений — ДВС-синдрома, печёночной недостаточности, неврологического дефицита.
Уход за пациентами при инфекционно-токсическом шоке одно из важных условий выздоровления. Это мероприятия по уходу за кожей, ротовой полостью, профилактике пролежней, туалету мочеполовой области.
Искусственное питание
Интенсивная терапия инфекционно-токсического шока невозможна без нутритивной поддержки. Этот термин обозначает комбинацию методов питания.
- Парентеральное питание проводится посредством внутривенного введения трёх компонентов — жиров, углеводов, аминокислот.
- Энтеральное питание предполагает введение смесей определённого состава через зонд в тонкий кишечник.
Нутритивная поддержка обеспечивает суточные потребности пациента, дефицит жидкости, микро и макроэлементов. Лучший способ восстановить функции желудочно-кишечного тракта, избежать осложнений в виде кровотечений — это энтеральное питание.
Инфекционно-токсический шок у детей
Наиболее тяжёлые формы ИТШ возникают у пациентов раннего возраста. По интенсивности симптомов заболевания распределились в следующей последовательности:
- менингококковая инфекция;
- кишечная инфекция;
- грипп;
- дифтерия;
- другие заболевания.
Инфекционно-токсический шок у детей отличается рядом особенностей.
- Быстро развивается обезвоживание, потеря электролитов на фоне рвоты, диареи, высокой температуры тела.
- Наибольшему риску развития ДВС-синдрома при инфекционно-токсическом шоке подвержены новорождённые.
- Особенности строения приводят к более тяжёлой острой дыхательной и сердечной недостаточности, гипотермии.
- Осложнением гипертермии становятся судороги.
Лечение инфекционно-токсического шока у детей проходит в условиях специализированного отделения. В реанимации для новорождённых пациентов выхаживают в специальных аппаратах — инкубаторах, которые можно при необходимости превратить в место для реанимации.
Инфекционно-токсический шок у беременных
Частой причиной сепсиса в акушерстве является инфицирование при родах или в послеродовом периоде. В группе риска находятся женщины с родовыми травмами, длительным безводным промежутком, затяжными родами.
В послеродовом периоде источником первичной инфекции могут стать маститы, абсцессы промежности.
При неэффективности консервативной терапии прибегают к оперативной санации гнойного очага.
Последствия
В основе патогенеза инфекционно-токсического шока лежит развитие полиорганной недостаточности. Интенсивная терапия включает сильнодействующие препараты, имеющие побочные действия. Поэтому даже на фоне эффективного лечения, возможны следующие последствия:
- желудочно-кишечные кровотечения;
- энцефалопатия, апаллический синдром — полная утрата познавательных функций головного мозга при сохранности основных вегетативных;
- вторичное присоединение инфекции;
- образование пролежней;
- полинейропатии — поражения периферической нервной системы;
- дисбактериоз;
- хронические заболевания печени, почек, желудочно-кишечного тракта;
- нарушения слуха, зрения.
На фоне нарастающей сердечной и сосудистой недостаточности может наступить остановка кровообращения. Избежать необратимых последствий поможет своевременное обращение к медицинским специалистам.
Инфекционно-токсический шок — это осложнение заболеваний, вызванных микроорганизмами. Присутствие их токсинов в крови активирует защитные механизмы иммунной системы. Но реакция выходит за пределы одного органа или системы, поэтому развивается состояние, угрожающее жизни человека. Интенсивная терапия инфекционно-токсического шока возможна только в условиях специализированного отделения. То, насколько быстро пострадавший попадёт в стационар, повлияет не только на дальнейший прогноз заболевания, но и на сохранение жизни.
Инфекционно-токсический шок